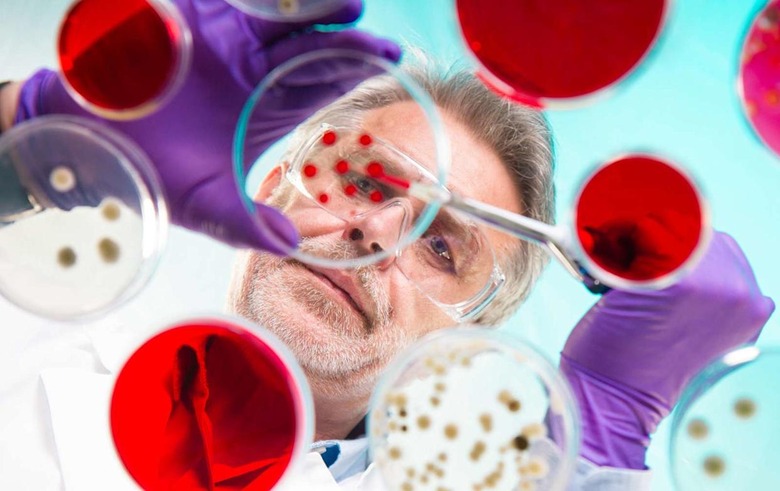

Programming language makes circuits out of bacteria
It's now easy to write DNA that does your bidding.
Biological circuits have been a reality for years. However, making them is no mean feat: you typically have to create everything from scratch, which is impractical for everyone but a specialized genetic engineer. MIT has a better way, though. It developed a programming language that makes it comparatively easy to produce these organic machines — you just write code (based on existing computer instructions) and get a bacteria-friendly DNA sequence that does what you want. In the lab, sample circuits in E. coli did everything from ranking inputs to measuring oxygen levels.
The early work is buggy. Out of 60 circuits, only 45 worked on the first try. Should everything go well, though, this could democratize genetics. You wouldn't need expertise in biology to custom-code DNA. In theory, even a high schooler learning the basics of programming could produce living circuits. Ultimately, this could lead to bacteria that solve specific conditions, such as reducing lactose intolerance (by improving digestion) or producing pesticide when bugs attack a plant.